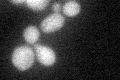
YIR036C
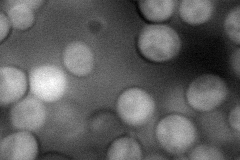
YIR036C
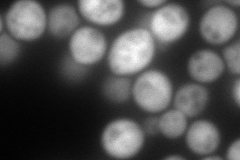
YIR036C
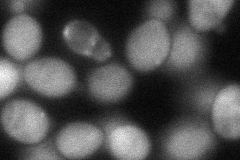
YIR036C
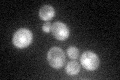
YIR036C

View description
Putative benzil reductase;(GFP)-fusion protein localizes to the cytoplasm and is induced by the DNA-damaging agent MMS; sequence similarity with short-chain dehydrogenase/reductases; null mutant has increased spontaneous Rad52p foci
Localization:
Intensity:
Fold change:
Significance:
-
C’ GFP library in SD
cytosol29.1 -
N' NOP1pr-GFP in SD
cytosol0 -
N' TEF2pr-mCherry in SD
cytosol248.189 -
N' NATIVEpr-GFP in SD

cytosol43.2512 -
N' TEF2pr-VC and Cyto-VN in SD
cytosol74.5974 -
C’ GFP library in SD+DTT

cytosol40.331.38Yes -
C’ GFP library in SD+H2O2

cytosol36.921.26No -
C’ GFP library in Starvation Media
cytosol53.371.83Yes -
C’ GFP library on the background of Pup2-DaMP

cytosol -
C’ GFP library on the background of CCT mutant

cytosol49.9161.71509Yes
